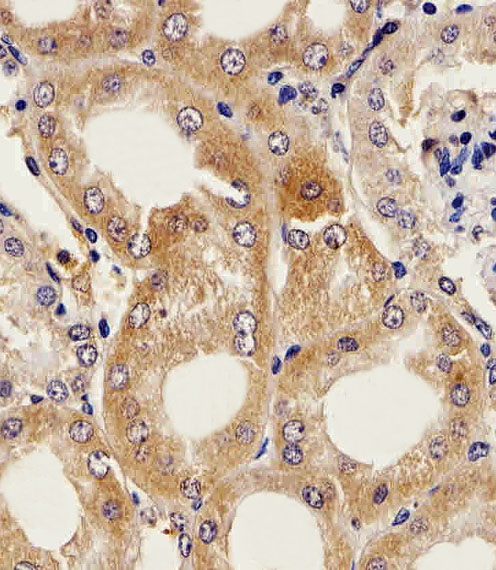
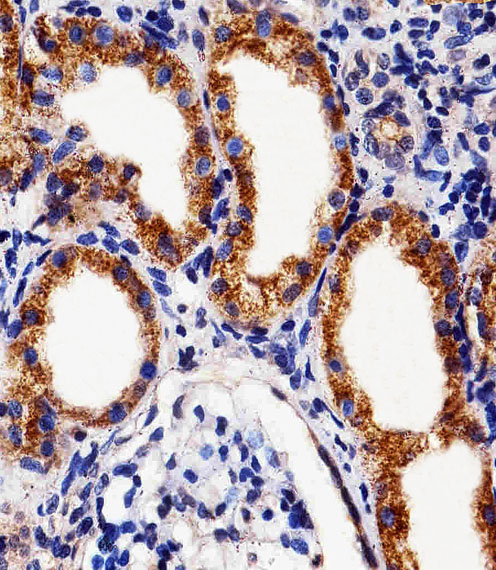

别名:DNA fragmentation factor subunit beta, 3—, Caspase-activated deoxyribonuclease, CAD, Caspase-activated DNase, Caspase-activated nuclease, CPAN, DNA fragmentation factor 40 kDa subunit, DFF-40, DFFB, CAD, DFF2, DFF40应用:WB,IHC,FCM
反应种属:Human, Mouse, Rat
规格:50μl/100μl
| Description |
|---|
| Nuclease that induces DNA fragmentation and chromatin condensation during apoptosis. Degrades naked DNA and induces apoptotic morphology. |
| Specification | |
|---|---|
| Aliases | DNA fragmentation factor subunit beta, 3—, Caspase-activated deoxyribonuclease, CAD, Caspase-activated DNase, Caspase-activated nuclease, CPAN, DNA fragmentation factor 40 kDa subunit, DFF-40, DFFB, CAD, DFF2, DFF40 |
| Entrez GeneID | 1677 |
| Swissprot | O76075 |
| WB Predicted band size | 39.1kDa |
| Host/Isotype | Rabbit IgG |
| Storage | Store at 4°C short term. Aliquot and store at -20°C long term. Avoid freeze/thaw cycles. |
| Species Reactivity | Human, Mouse, Rat |
| Immunogen | This DFFB antibody is generated from a rabbit immunized with a KLH conjugated synthetic peptide between 203-238 amino acids from the Central region of human DFFB. |
| Application | |
|---|---|
| WB | 1/1000 |
| IHC | 1/100-1/500 |
| FCM | 1/25 |
 |
Western blot analysis of lysate from A431 cell line, using DFFB Antibody (Center)(Cat. #P32643). P32643 was diluted at 1:1000. A goat anti-rabbit IgG H&L(HRP) at 1:5000 dilution was used as the secondary antibody. Lysate at 35ug. |
 |
Flow cytometric analysis of Hela cells using DFFB Antibody (Center)(green, Cat#P32643) compared to an isotype control of rabbit IgG(blue). P32643 was diluted at 1:25 dilution. An Alexa Fluor® 488 goat anti-rabbit lgG at 1:400 dilution was used as the secondary antibody. |
|
Immunohistochemical analysis of paraffin-embedded M.kidney section using DFFB Antibody (Center)(Cat#P32643). P32643 was diluted at 1:25 dilution. A peroxidase-conjugated goat anti-rabbit IgG at 1:400 dilution was used as the secondary antibody, followed by DAB staining. |
|
Immunohistochemical analysis of paraffin-embedded H.kidney section using DFFB Antibody (Center)(Cat#P32643). P32643 was diluted at 1:25 dilution. A peroxidase-conjugated goat anti-rabbit IgG at 1:400 dilution was used as the secondary antibody, followed by DAB staining. |
本公司的所有产品仅用于科学研究或者工业应用等非医疗目的,不可用于人类或动物的临床诊断或治疗,非药用,非食用。
暂无评论
本公司的所有产品仅用于科学研究或者工业应用等非医疗目的,不可用于人类或动物的临床诊断或治疗,非药用,非食用。
 中文
中文 








发表回复